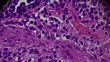

Chronische appendicitis pathologie onder de lichte microscopie - 4K Stockvideo
Chronic appendicitis pathology under light microscopyzoom in different areas.

LICENTIE KOPEN
Alle royalty free licenties bieden wereldwijde gebruiksrechten en uitgebreide bescherming. Daarnaast zijn er eenvoudige tarieven met volumekortingen beschikbaar.
€ 475,00
EUR
GEGEVENS
Credits:
Creatief nr.:
904562962
Soort licentie:
Collectie:
Creatas Video
Max. bestandsgrootte:
3840 x 2160 px - 779 MB
Lengte van clip:
00:00:12:00
Datum van uploaden:
Locatie:
China
Release-informatie:
Geen release vereist
Gemastered naar:
QuickTime 8-bit Photo-JPEG 4K 3840x2160 25p
Categorieën:
- Microscoop,
- Cel,
- 4K-resolutie,
- Abstract,
- Anatomie,
- Biologie,
- Biopsie,
- Blindedarmontsteking,
- Buiten de VS,
- China - Oost-Azië,
- Chronische ziekte,
- Dier,
- Doktersonderzoek,
- Dood - Begrippen,
- Doorsnede,
- Fysiologie,
- Gezondheidszorg en medicijnen,
- Histologie,
- Horizontaal,
- Hormoonklier,
- Kanker,
- Kankergezwel,
- Laboratorium,
- Landschap - Natuur,
- Lichtmicroscopische foto,
- Macrofotografie,
- Medicijnen,
- Medisch onderzoek,
- Medische aandoening,
- Menselijk lichaamsdeel,
- Menselijke klier,
- Mensen,
- Microbiologie,
- Morfologie,
- Objectglaasje,
- Onderwijs,
- Onderzoek,
- Patholoog,
- Patiënt,
- Pijn,
- Religieus kruis,
- Speelfilm,
- Spoedeisende geneeskunde,
- Straling,
- Textures-effect,
- Vergroting,
- Weefsel,
- Wetenschap,
- Wetenschappelijk experiment,
- Ziekte,
- Zoomeffect,